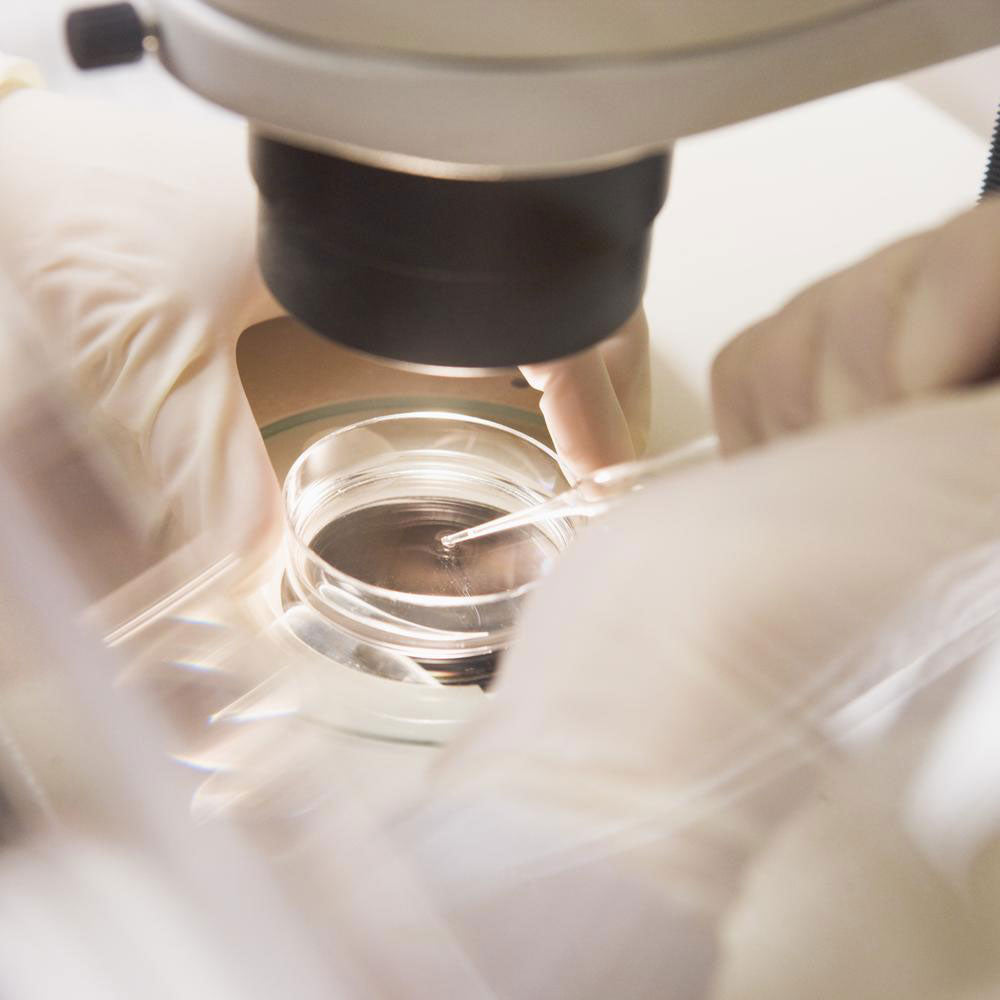
Abiorevitalization Ano Cosmetic Surgery Of The Face: Synergies Of Action

Rejuran® Healer Turnover Ampoule Clinical Testing
REJURAN® Healer Turnover Ampoule Clinical testing - Korea Dermatological Research Institute (click link here)
Summary of Clinical Research
This clinical research and test results related to the REJ...

Effects of Polydeoxyribonucleotide in the Treatment of Pressure Ulcers
Effects of Polydeoxyribonucleotide in the Treatment of Pressure Ulcers
Abiorevitalization Ano Cosmetic Surgery Of The Face: Synergies Of Action
BIOREVITALIZATION ANO COSMETIC SURGERY OF THE FACE: SYNERGIES OF ACTION

Comparison of wound healing effects polydeoxyribonucleotide (PDRN) between Oncorhynchus keta-derived PDRN
Comparison of wound healing effects polydeoxyribonucleotide (PDRN) between Oncorhynchus keta-derived PDRN


